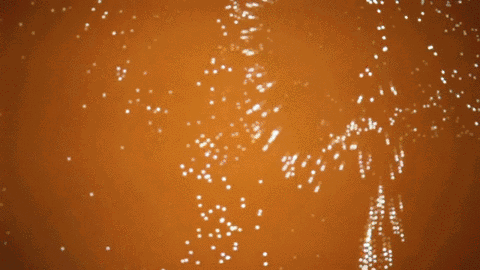
47.gif

互動景觀玩不到,可以看夠!
上周小石頭分享的《公共空間互動裝置既好看又好玩》大家是否都還記憶猶新?是不是都有種還沒有看過癮的趕腳呢,今天再來一波福利,話不多說,一起來飽飽眼福,玩不到的,可以看夠!戳下方啦~
如何讓你的場地更加吸引人而脫穎而出?
有些人做很多奇思構(gòu)想的構(gòu)筑物,
有些人花很多心思在場地細節(jié)上,
你也可以增加場地與人的互動性。
TIFF(多倫多國際電影節(jié))機器人


以色列藝術(shù)家 Daniel Rozin 的互動裝置-企鵝鏡

一種特殊感壓裝置,透過感測器和電腦程式,讓藝術(shù)品以機械動態(tài)、物件組合映射出觀眾的樣貌圖像,如照鏡子一般,“鏡”中的成像也會隨著觀者的動作即時呈現(xiàn)。
這款裝置最神奇的是,這些鏡子并非是以鏡面材質(zhì)制作的,而是諸如垃圾、編織袋、蓬蓬絨毛,甚至企鵝......

由450只會旋轉(zhuǎn)的機器企鵝所組成。利用企鵝腹背黑白顏色的對比,互動者只要站在裝置前面動作,可愛的企鵝們就會跟隨影子互動,進而將互動者的動作排列出來,真的是太可愛了!

以色列藝術(shù)家 Daniel Rozin 的互動裝置-蓬蓬鏡

蓬蓬鏡也叫毛茸茸鏡,是由928顆可愛的黑白毛球,并以464顆馬達來驅(qū)動組成的這件作品,在感應(yīng)到你的形態(tài)后,會迅速做出黑白配的反應(yīng)。毛球轉(zhuǎn)動的時候整件作品仿佛活了過來,據(jù)說現(xiàn)場體驗有種相當詭異的趕腳。

不管是《企鵝鏡》或者《毛茸茸鏡》,藝術(shù)家用獨特的幽默感,賦予科技“柔軟”的溫度,觀者能從鏡中看見自己截然不同的面。

角度鏡
三角的鏡框里面,是若干個角度可調(diào)的棍子。站到作品前,找到一個正確的調(diào)度,即可開始控制這些小棍子。讓它們?yōu)槟愕拿烂菜?ldquo;傾倒”!

東京原宿咖啡店里的巨型互動裝置

韓國銳步地鐵比賽

神奇的海上互動裝置


THéORIZ 工作室的“門”


Ice Angel


Portée多感官體驗


光感古琴

乒乓球臺


美二手車交易平臺Autotrader互動3DMapping裝置

當行人站在裝置前面時,裝置會識別用戶身上衣服的顏色,然后神奇的事情就發(fā)生了。


漢城“D博物館"互動裝置——我的鯨魚


法航發(fā)現(xiàn)法國藝術(shù)之旅



浮舟錦鯉蓮花間

在樂園的池塘里,虛擬的蓮花盛開著,錦鯉遨游其中,處處充滿生機。

變幻莫測的畫面,色彩斑斕,仿佛身處童話世界。

受人們現(xiàn)場各種即時行為的影響,電腦程序?qū)Τ靥晾锏娘L景進行著實時描繪。

水面的每一寸漣漪都能被感應(yīng)到,投射在水面上的鯉魚可以和漂浮的小船進行互動。

它們并沒有意識,但卻會隨著小船的運動而產(chǎn)生相應(yīng)的變化。

如果小船靜止地浮在水面,魚兒們就會聚集到小船旁;如果小船有擺動,它們則紛紛閃避。

每一條魚的行為還會影響到周圍的同伴。它真實地模擬了現(xiàn)實中魚兒的自在戲水的場景,實在妙趣橫生。

觸手可及的巨型“萬花筒”互動燈光藝術(shù)裝置


Adobe Summit 2016愉快體驗


大雨、聲音和發(fā)光體

一個為自閉癥兒童設(shè)計的互動裝置
展廳中每一顆雨滴上方都連接有一個振動傳感器,人們輕拍雨滴產(chǎn)生的振動將激活傳感器,使雨滴改變色彩,而預先編好的程序同時將控制其他雨滴變成相應(yīng)的顏色,形成一種光的傳遞的效果。

Universe of Water Particles

當人站在瀑布上時他們會阻礙水的流動,就像巖石一樣,讓水流發(fā)生變化。

澳洲南十字火車站互動裝置

仲夏夜之夢流轉(zhuǎn)的光華


可以感應(yīng)人體的流砂互動裝置

砂子的潮流毫不間斷地以一定節(jié)奏不斷前進,而花朵也是接連不斷地誕生丶腐朽,然後再誕生。當觀賞者站立在流落的砂流面前時,砂子會因感應(yīng)到觀賞者的存在感而產(chǎn)生沖突,砂流便會出現(xiàn)一個被分割開的空間,在砂流對面的花朵會依照月份不同而進行變化。

神奇的布料游戲


澳大利亞Cabrini醫(yī)院入口處的LUMES互動墻

本來一面平淡無奇的墻,突然間因為你的經(jīng)過讓讓上面的燈光圖案生動起來,更好玩的是,你還能跟它進行互動!可以是你喜歡的菠蘿,也可以是你喜歡的花朵,絕對讓你眼前一亮。在這種夢幻的童話世界里,生病的寶寶會處于一種開心樂觀的狀態(tài)。


Google 辦公室

這個高科技巨大互動屏幕,能夠顯示各種各樣的動態(tài)效果,任何人都可以利用并修改代碼和方案,從而打造任何規(guī)模或任何專業(yè)水準的定制屏幕,就看程序猿們有多能了。11種演示應(yīng)用都可以在演示庫里找到,老少皆宜,簡直為Google的員工們創(chuàng)造了一個娛樂天堂。


赫茲利亞當代藝術(shù)博物館Human Sound項目

深一腳,淺一腳,腳下漣渏擴散中,有著美妙的音節(jié)隨行。這是一個名為Human Sound的交互項目,每一個人都可以成為樂曲的創(chuàng)作者。變幻腳下的步伐,投影會隨著人們的動作變化,仿佛聲波一樣擴散。而音樂也會隨之響起。


雜音互動裝置:將聲音轉(zhuǎn)換為光


福岡Canal City Hakata購物中心燈光裝置

在福岡Canal City Hakata購物中心的巨大燈光裝置,用戶可以使用手機來控制燈光的特效。同時現(xiàn)場也會有主控制設(shè)備,用戶可以滑動一些特效來控制燈光展。

上海城市空間互動裝置 聲動竹林

當人走過這條燈光竹林小徑的時候,或者大聲說話的時候,或者是踩動底板的時候,它的顏色就會從白色的光線慢慢的轉(zhuǎn)換呈綠色。

會跳舞的樹林


互動樓梯


燈光與音樂的互動讓上下樓梯變成一種樂趣

特別是戶外公共空間,高高樓梯令人望而卻步




當讓互動成為一種引導 ,再多的臺階也不覺得累

北京五道口宇宙中心廣場


波浪水臺效果


耐克公司互動式投影裝置


充滿想象的數(shù)字互動裝置



一個身臨其境的視聽裝置



廣場旋轉(zhuǎn)的椅子

日本秋田TDK美術(shù)館內(nèi)的teamLab裝置


交互式虛擬游戲裝置



大自然的黑膠唱盤機

能刷卡的廣告牌

一枚硬幣的力量



D-bug新媒體互動裝置
東京麥當勞互動裝置


泰瑞廣場感應(yīng)視頻播放裝置

一件面積高達1700平方英尺的活動感應(yīng)視頻播放裝置,裝置會隨著過往行人的移動而變化。

三塊顯示屏在《季節(jié)》、《色彩游戲》和《城市風光》三個主題之間來回切換,呈現(xiàn)一系列不同的畫面,當屏幕處于《季節(jié)》模式時,顯示屏播放了華盛頓區(qū)標志性的櫻桃樹四季生命周期。

發(fā)光蹺蹺板

蹺蹺板原本都是童心永存的象征,創(chuàng)作人員再在每一塊蹺蹺板上加上LED光帶,讓這里似乎變成了童心未泯的圣地。而且,更有趣的是,蹺蹺板還會發(fā)出音樂,由多倫多作曲家 Mitchell Akiyama 創(chuàng)作。隨著你在蹺蹺板上的上下起伏,蹺蹺板燈的強度和音樂聲也會隨之改變,讓你感知來自你身體節(jié)奏的獨一無二的回響,仿若穿越到那兩小無猜的當年。

Loop互動性燈光藝術(shù)裝置

每個裝置有2米寬的圓筒,人們進入里面就可以驅(qū)動該機器。當兩人在里面以及來回拉動杠桿時,這個圓筒就開始旋轉(zhuǎn)。

當機器開始旋轉(zhuǎn)時,它就開始發(fā)亮,而且24個與童話相關(guān)的黑白圖畫也會隨著移動。拉動杠桿也會啟動音樂,隨著黑白圖片的轉(zhuǎn)換產(chǎn)生閃光效果,就像電影自動放映一樣。

美國魚腹互動裝置


該項目是由層層磨砂丙烯制材料組成,白天期間,該項目呈半透明性,完全看不出有任何的解剖效果,而到了晚上,它轉(zhuǎn)變成一個生物性的發(fā)光景觀。


波士頓swing time秋千裝置



皇冠噴泉



交互式動態(tài)裝置:塑料模仿

該作品由601塊來自世界各地不同海洋的塑料組成。這個裝置使用了601個防水引擎組成像素網(wǎng)格,還帶有用來捕獲周圍的觀眾輪廓和移動的運動傳感器。
為了讓觀眾意識到必須控制日益嚴重的塑料垃圾問題的影響,藝術(shù)家通過藝術(shù)品把這個問題展現(xiàn)了出來。

(哦 大家不要誤會 小石頭不給任何金主爸爸打廣告 除非給我一個億···)
聲明:本圖文分享自網(wǎng)絡(luò),小石頭整理編輯,轉(zhuǎn)載請注明來源,僅供學習與交流,版權(quán)為原作者所有。若發(fā)現(xiàn)侵犯到閣下版權(quán)權(quán)益,請聯(lián)絡(luò)小石頭電郵2355603338@qq.com




